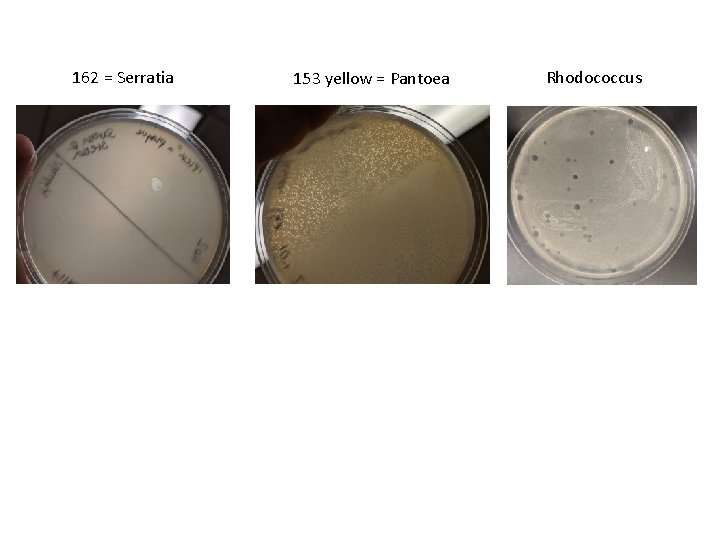

Rock pool 153 yellow Pantoea sp 153 VV















- Slides: 15

Rock pool #153 yellow = Pantoea sp. 153 VV isn’t working? ? Rock pool #162 Todd? 162 = Serratia sp.
162 = Serratia 153 yellow = Pantoea Rhodococcus

Bacteria characterization Gram stain: phenotypic characterization that differentiates organisms by cell wall structure 16 s r. RNA sequencing: molecular characterization that differentiates organisms by the sequence of a highlyconserved gene

Bacteria cell wall structure

Gram stain: phenotypic characterization that differentiates organisms by cell wall structure Gram negative Gram positive Fixation Crystal violet Iodine treatment Decolorizer Counter stain safranin

16 s r. RNA sequencing: molecular characterization that differentiates organisms by the sequence of a highly-conserved gene Ribosome is composed of 3 RNAs + 52 proteins 16 s r. RNA recognizes ribosome binding site

16 s r. RNA sequencing: molecular characterization that differentiates organisms by the sequence of a highly-conserved gene DNA purification: Bacteria lysis Bind DNA to column Wash through proteins/salt Elute DNA PCR to amplify region of interest Submit DNA to core facility for sequencing

ma rke r Sam ple Sam 1 ple 2 16 s r. RNA sequencing: molecular characterization that differentiates organisms by the sequence of a highly-conserved gene 1000 bp 500 bp

Phage characterization Purification of phage by serial dilution and plaque assay Objective: Obtain a clonal phage population Allows you to discover biological properties of phage Morphology Plaque size and shape Genome sequence Which plate(s) show clonal plaque morphologies?

Phage characterization Purification of phage by plaque assay

Phage characterization Purification of phage by plaque assay Typically 104 to 108 phage/m. L

Phage characterization Purification of phage by serial dilution and plaque assay Protocol 6. 2 Serial Dilution -pipet to make 10 -fold dilutions of your enrichment filtrate Protocol 5. 3 Plaque Assay -infect bacteria cultures with dilutions and plate with top agar

Serial dilution Go back to your enrichment filtrate- in rack in fridge. ENRICHED SAMPLE This is your 100 undiluted phage sample. Typically e 4 – e 8/ml 10 -fold dilutions Set up 10 -fold dilutions Phage concentration e 3 – e 4/ml

Plaque Assay Serial Dilutions Undiluted 10 -1 10 -2 10 -3 10 -4 10 -5 10 ml diluted filtrate Bacteria aliquots Plate with top agar Undiluted 10 -1 10 -2 10 -3 10 -4 10 -5
